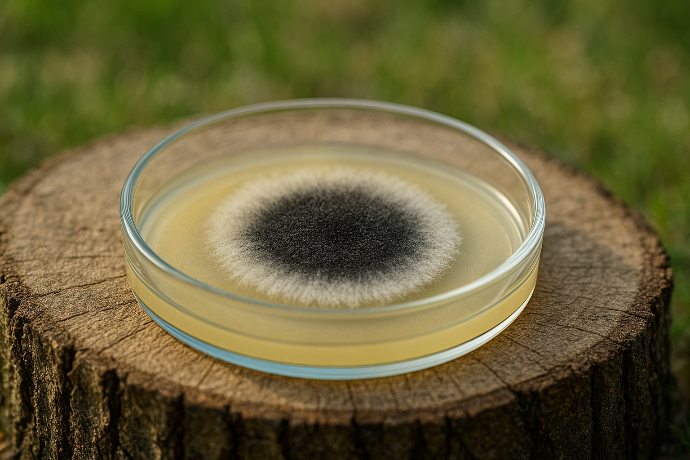
Chitosan HD ex Aspergillus Niger P. (18597) Cosmetics

Chitosan HD ex Aspergillus Niger P. (18597) Cosmetics
Scientific name:
Aspergillus Niger
Sales description:
Chitosan powder from Aspergillus Niger
Qualität:
for cosmetics
Part used:
mycelium
Carrier:
None
Solubility:
acid-soluble
CAS No.:
9012-76-4
Synonyms:
Chitosan
Origin:
China
Download Data Sheet:
Download
Ihr dynamisches Snippet wird hier angezeigt ...
Diese Meldung wird angezeigt, weil Sie weder einen Filter noch eine Vorlage zur Verwendung bereitgestellt haben.